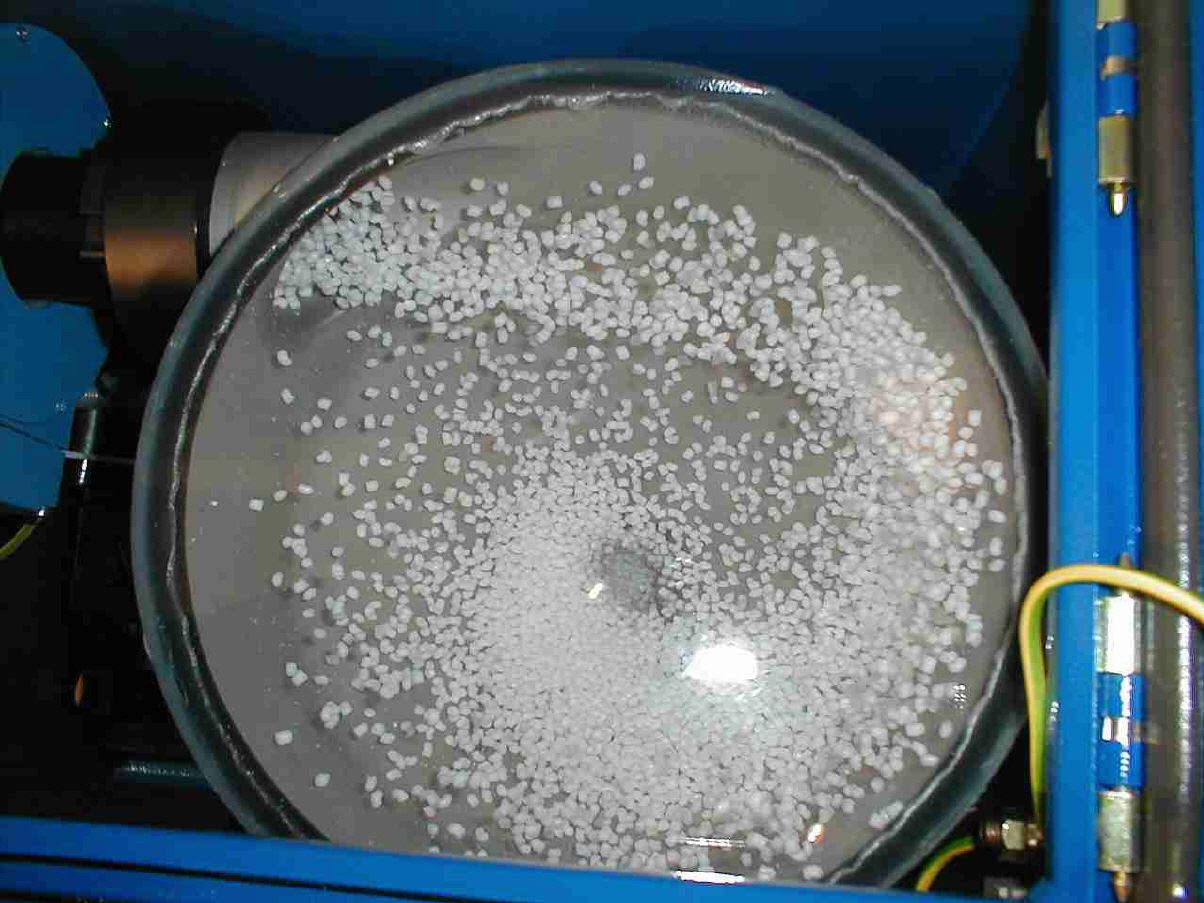

Der Metallabscheider für Vacuumförderung
Dieser Metallabscheider entfernt auch bei variabler Materialgeschwindigkeit Metallrückstände aller Art vollautomatisch aus dem Produktstrom. Der Metallextraktor nutzt dazu eine justagefreie Zyklontechnologie.
Technische Daten
Einsatzbereich: Vacuumförderleitungen DN 38 - 70mm
Standard Netzspannung : 230V/50Hz
Druckluftversorgung : 4 - 6 bar
Materialdurchsatz : je nach Geräteetype bis zu 3.300 l/h*
Detektionsgenauigkeit : ab circa 0,3mm FE-Kugel/0,5mm VA-Kugel *
Gehäuseabmessungen : 450*450*300 (L*B*T) in mm
Gewicht circa : 32 kg
Einsatztemperatur : 0 - 60 Grad(höhere Temperaturen auf Anfrage)
Zulässige Materialkorngrösse : 0,1 - 8mm (Material kann vorab geprüft werden)
Materialeigenschaften: Rieselfähig, trocken.
ACHTUNG !
Ab Mai 2022 : Gehäusefarbe in Kaminrot RAL 3002 und nicht mehr in Blau RAL 5005.
Bei elektrisch leitfähigen oder abrasiven Fördergut teilen Sie uns das bitte mit Ihrer Angebotsanfrage mit.
Technische Änderungen sind jederzeit möglich.
* variieren je nach Rahmenbedingungen der gesamten Anlage ,den Materialeigenschaften, der eingesetzten Gerätetype und Auswerteelektronik und den Parametereinstellungen.
Das Funktionsprinzip und die Vorteile gegenüber anderen Systemen.
Warum lösen Sie Ihr Problem nicht wirtschaftlicher und effektiver ?

|
Stoppen Sie Eisenpartikel vor dem Allmetallabscheider mit dem schirp MAG 14000® Neodym Magneten ! Das reduziert die Separiervorgänge des Allmetallabscheiders ! Der Magnet stoppt feinste FE Partikel >0,1 mm und ist diesem Punkt jedem Allmetallabscheider weit überlegen! |

|
Zur Reinigung des Magneten wird dieser einfach für einen Förderzyklus kurz von Leitung genommen ! Der Allmetallabscheider wirft das gesammelte Eisen aus ! Diese geniale Kombination ist patentrechtlich geschützt mit dem EU-Patent No 238 30 39 und somit einzigartig im Markt ! |
Die Vorteile
Geringster Materialverlust beim Separiervorgang durch zeitgleiche Unterbrechung des Förderstroms.
Justagefreie Zyklontechnik
Automatische Reinigung aller produktberührenden Teile per Druckluft, damit kein Restmetall im Inneren verbleibt.
Einfache Integration in Materialförderleitungen von 38 - 70mm
Kompakt und platzsparender Aufbau.
In Kombination mit unserem schirp MAG14000® System wird der Materialverlust gesenkt und der Reinigungsgrad für Eisenpartikel erhöht.
Schnelle Reinigung da Zyklondeckel und zwei Inspektionstüren alle Teile gut zugänglich machen.
Test der Gerätefunktion auf Knopfdruck
Zentral eingesetzt schützt das System mehrere Maschinen.
Glas Verschleisschutz für abrasive Produkte als Option lieferbar
Mahlgut - Aufarbeitung
Aufgrund Platzmangel suchte der Kunde eine Lösung, die er an jedem anderen Ort der Produktion aufstellen kann. Eine fahrbare Allmetallabscheider Anlage war die Lösung.
Referenzschreiben vom Kunden